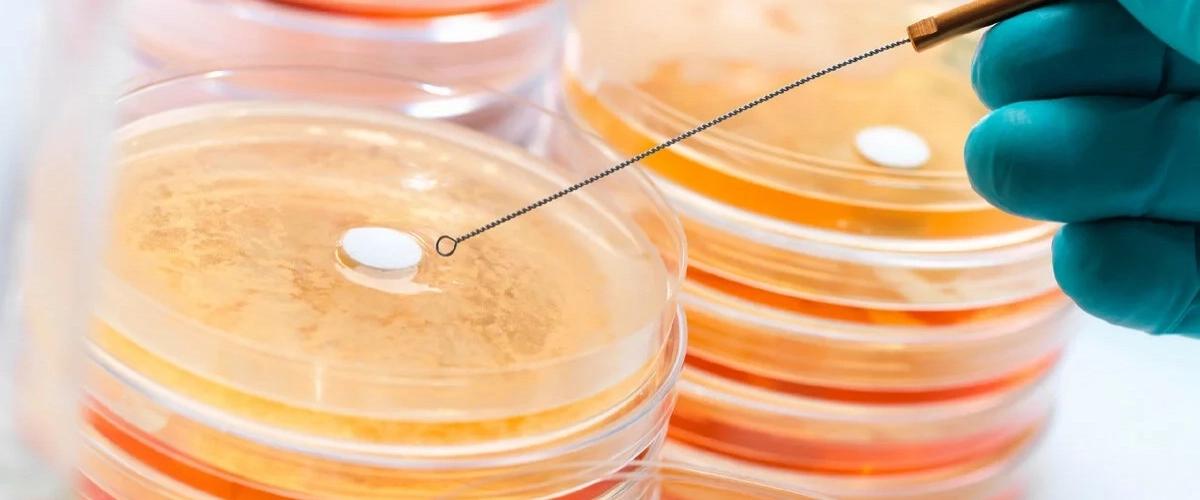

Синтетическое соединение инфузид разрабатывала более десяти команда из Великобритании, Франции и Индии. Эксперименты привели ученых к созданию инфузида, который показал активность против грамположительных бактерий — золотистого стафилококка и энтерококка, сообщается на сайте Американской ассоциации микробиологии. Оба патогена могут вызывать тяжелые инфекции и связаны с повышенными рисками развития резистентности к антибиотикам.
Эксперименты продемонстрировали, что инфузид действовал быстрее антибиотиков и эффективнее уничтожал бактериальные колонии. В комбинации с уже существующим антибиотиком линезолидом эффективность лечения была еще выше.
Пока инфузид не показал аналогичной эффективности прости грамотрицательных бактерий, однако ученые планируют внести несколько модификаций для усиления препарата и расширения его антимикробной активности. В случае успеха инфузид может стать альтернативой многим антибиотикам, которые быстро теряют эффективность при встрече с супербактериями
Ранее другие ученые показали, что сахарин уничтожает устойчивые бактерии. Он действует подобно антибиотикам и разрушает бактериальные стенки.